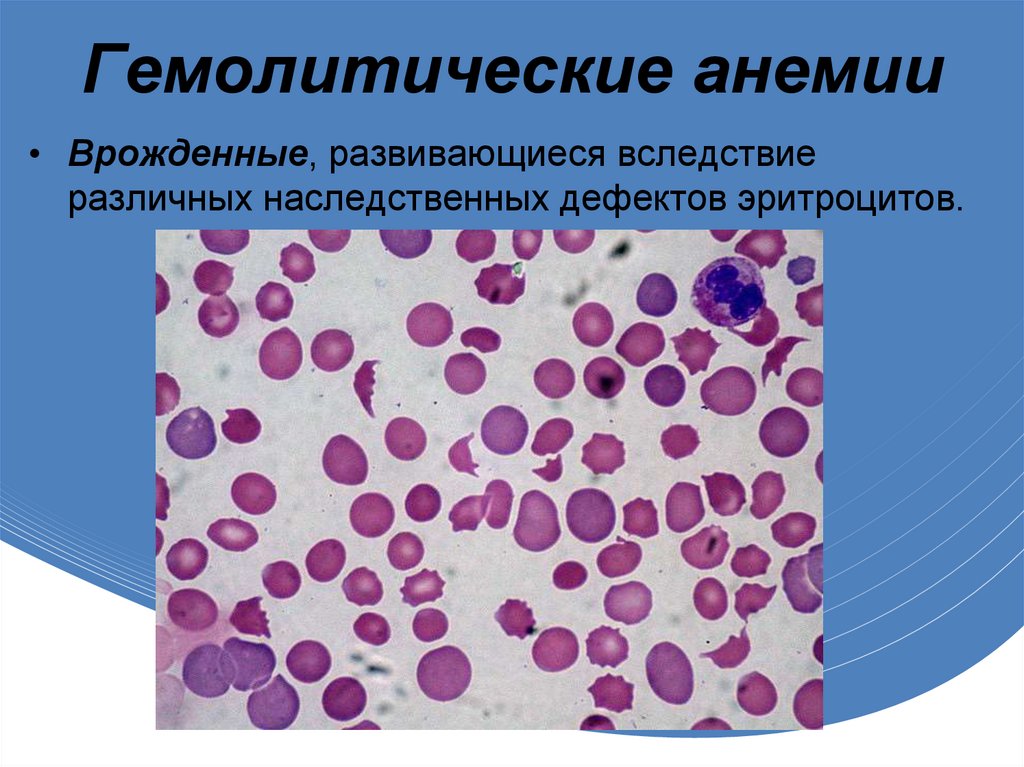

Similar presentations:
Патология системы крови. Анемии
1.
ФГБОУ ВОНижегородская сельскохозяйственная академия
Тема: «Патология системы крови. Анемии.»
по дисциплине «Патологическая физиология»
Подготовил:
Студент 3 курса
ветеринарного факультета
группы 149
Подъелышев Павел
2022г
2.
Анемия• Это не самостоятельное
заболевание, а
патологическое
состояние,
характеризующееся
снижением содержания
гемоглобина и, зачастую,
количества эритроцитов в
единице объема крови,
что приводит к
уменьшению транспорта
кислорода к тканям.
3.
Истинная анемия• Определяется как уменьшение количества
эритроцитов в крови, при этом такие
показатели крови, как процентное
соотношение объема эритроцитов к объему
плазмы (гематокрит) и концентрация
гемоглобина в эритроцитах находятся
обычно также ниже нормальных показателей.
Данный вид анемии может быть
замаскирован сопутствующим
обезвоживанием организма.
4.
Относительная анемия• Обычно возникает при перенасыщении организма
животного жидкостью (гипергидратации). Задержка
эритроцитов в селезенке и в других депо крови
(например, в печени) также может стать причиной
относительной анемии.
5.
Постгеморрагическиеанемии
• Острая постгеморрагическая анемия является
следствием быстрой потери значительного количества крови
при травмах, кровотечении (желудочном, кишечном,
маточном), разрыве гемангиосаркомы или опухолей
надпочечников с кровоизлияниями в полости тела и ткани и
др. Анемия вследствие кровопотери не всегда очевидна. Если
явных травм и кровотечения нет, необходимо с помощью
подробного анамнеза, обследования и лабораторных тестов
исключить вероятность скрытых (внутренних) кровотечений.
При наружном кровотечении в первые моменты после
массивной кровопотери, несмотря на уменьшение общего
объема крови, гематокрит и общее содержание белков в
плазме не меняется. Это обусловлено пропорциональной
потерей эритроцитов и плазмы.
6.
• Хроническая постгеморрагическая анемия развивается врезультате длительных постоянных кровопотерь (даже в
незначительном объеме) при язвах и опухолях желудочно-кишечного
тракта, паразитарных заболеваниях.
При хроническом кровотечении нарастает недостаточность железа,
чаще всего это свойственно собакам, т.к. паразитарные инвазии,
вызывающие хроническую кровопотерю, возникают у них гораздо
чаще, чем у кошек.
7.
Гемолитические анемии• Врожденные, развивающиеся вследствие
различных наследственных дефектов эритроцитов.
8.
• Приобретенные, развивающиеся вследствие:снижения содержания фосфатов в крови при инсулинотерапии
животных с кетоацидозом (кошки, собаки), липидозе печени у кошек,
нарушении диеты (перекармливание);
отравления растениями и химическими агентами: метиленовым
синим, нитритами, ядами змей (кошки, собаки); метионином и
пропиленгликолем (кошки);
гемолиза, обусловленного паразитами (микоплазмы, бабезии,
гемобартонеллы, лептоспиры).
иммуноопосредованного гемолиза при аутоиммунной
гемолитической анемии (в основном собаки), системной красной
волчанке (собаки), переливании несовместимой крови (собаки,
кошки).
9.
Железодефицитные• Обусловленные дефицитом железа в организме
животного (при кровопотере, недостаточном
поступление с пищей, нарушение его всасывания в
тонком кишечнике или повышенной потребности в
период роста, беременности и лактации).
10.
Фолиеводефицитныеанемии
• Эти анемии обусловлены
недостаточным
поступлением в организм
или невозможностью
утилизации витамина В12
и фолиевой кислоты,
обладающих
гемостимулирующими
свойствами. Витамин В12
и фолиевая кислота
участвуют в процессе
образования эритроцитов.
11.
Гипо- и апластические• Анемии, которые характеризуются уменьшением
продукции всех клеток костного мозга.
Возникают эти анемии при снижении образования
эритроцитов (эритропоэзе) или образовании дефектных
эритроцитов.
12.
• Они могут быть обусловлены сочетанием двух и болееэтиологических факторов. Лечение такого рода
заболеваний особенно сложное, т. к. часто не
представляется возможным выделить ведущий
патогенетический фактор, что сильно снижает
эффективность лечения и ухудшает прогноз.
В норме, при снижении количества эритроцитов, в крови
происходит активная реакция костного мозга в виде
выброса в кровь молодых форм эритроцитов –
ретикулоцитов. Их количество пропорционально степени
анемии. При нарушении функции костного мозга
выработка ретикулоцитов или недостаточная, или вообще
отсутствует.

medicine
medicine








